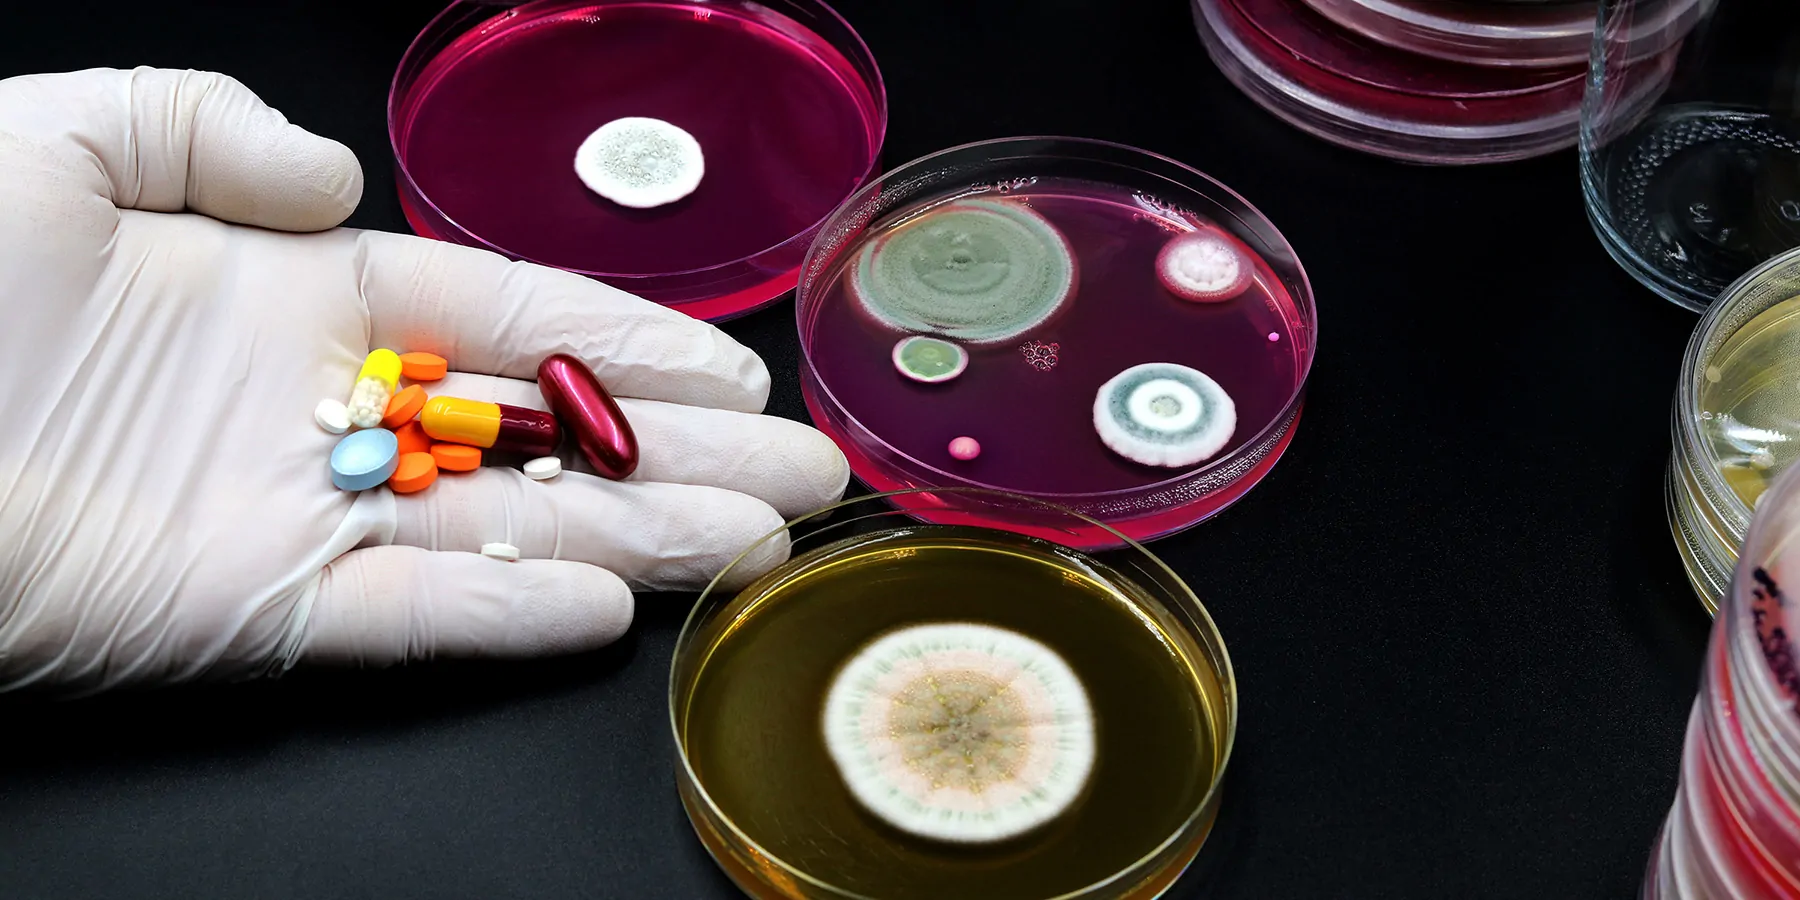
A gloved hand holding a bunch of colored medicine capsules before culture plates with various microorganisms' growth.

New WHO Report Highlights Progress, Gaps in Strategies to Combat AMR
Antimicrobial resistance was associated with nearly five million deaths in 2019, yet new antibiotics pipeline remains thin
The WHO, in partnership with the Global AMR R&D Hub, has released a report for G7 Finance and Health Ministers detailing progress on incentivizing the development of new antibacterial treatments. The Global AMR R&D Hub is a partnership of countries, nongovernmental donor organizations, and intergovernmental organizations to address challenges and improve coordination and collaboration in global antimicrobial resistance (AMR) R&D using a One Health approach.
The report follows commitments made in 2021 and 2022 by G7 Finance and Health Ministers to expedite the implementation of existing AMR strategies, take additional steps to address antibiotic market failure, create economic conditions to preserve the effectiveness of essential existing antibiotics and ensure their access, strengthen AMR research and development, and bring novel antibacterial medicines to market that cater to public health needs.
Following their 2023 meeting, the G7 Finance Ministers committed within their communiqué to “monitor, coordinate and enhance G7 efforts to incentivize AMR R&D, we reiterate our commitments building on the G7 Finance Ministers’ Statement of December 2021 on actions to support antimicrobial development and support the ongoing work of the G7 Health, Finance, Agriculture and Environment Tracks on AMR, including exploring the possibility of international collaboration on pull incentives for antimicrobial R&D, as appropriate. We welcome this year’s AMR progress report by WHO and the Global AMR R&D Hub in this regard. We continue to build on and implement previous G7 Finance and Health Ministerial commitments on strengthening antibiotic innovation.”
The G7 Health Ministers communiqué amplified the commitment saying “to this end, we continue to commit to exploring and implementing push and pull incentives that promote investment in R&D of antimicrobials, including contributing to existing global pooled efforts, such as CARB-X, GARDP, and SECURE, at the earliest opportunity and within reasonable and feasible timelines. In addition to investing in R&D, we will promote solutions that address the antimicrobial pipeline, protect and work toward maximizing the effectiveness of existing antimicrobials through antimicrobial stewardship for prudent and appropriate use and diagnostics to enable effective stewardship, and safe disposal of antimicrobials in both human and animal, in line with the One Health approach.”
AMR remains one of the top 10 global public health threats facing humanity, associated with the deaths of nearly 4.95 million people in 2019. AMR is also a threat to the global economy, with an impact on international trade, health care costs, and productivity predicted. If no action is taken, AMR could cost the world’s economy a whopping $100 trillion by 2050.
According to the WHO’s annual review of antibacterial agents in clinical and preclinical development, the R&D pipeline for new antibacterial medicines is insufficient to tackle the challenge of increasing emergence and spread of antibiotic resistance. Furthermore, the availability and access to new and existing antibiotics, including generics, is a challenge for countries of all income levels. The Global Leaders Group on AMR—a group of world leaders and experts from across sectors working together to accelerate political action on AMR—recently reiterated that the world faces a serious antibiotic pipeline and access crisis that requires innovative financing measures.
Substantial progress has been made by G7 countries to support research and development, particularly by increasing investments and creating new incentive mechanisms. However, current efforts remain insufficient to address the antibiotic pipeline and access crisis. In particular, efforts to ensure equitable access to antibiotics in low- and middle-income countries that experience the highest burden of AMR are lacking.
The report proposes a set of priority actions to accelerate progress over the next two years. These include working towards relevant commitments and targets for the high-level meeting on AMR at the United Nations General Assembly in 2024; encouraging alignment and targeted action on financing mechanisms to address the antibiotic R&D and access crisis; and bolstering equitable and global access to antibiotics addressing the most urgent public health needs.
- This press release was originally published on the World Health Organization website